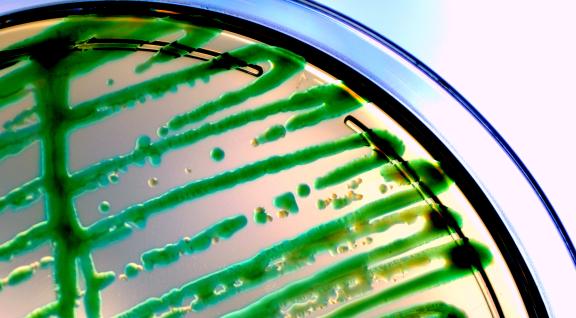
Petrischaal

Knelpunt ‘Zelfstandige leesbaarheid van ggo-dossiers’ opgelost
Het knelpunt ‘Zelfstandige leesbaarheid van ggo-dossiers’ is opgelost en de criteria voor het gebruik en aanleveren van informatie ten behoeve van het uitvoeren van een risicobeoordeli

Het knelpunt ‘Zelfstandige leesbaarheid van ggo-dossiers’ is opgelost en de criteria voor het gebruik en aanleveren van informatie ten behoeve van het uitvoeren van een risicobeoordeli